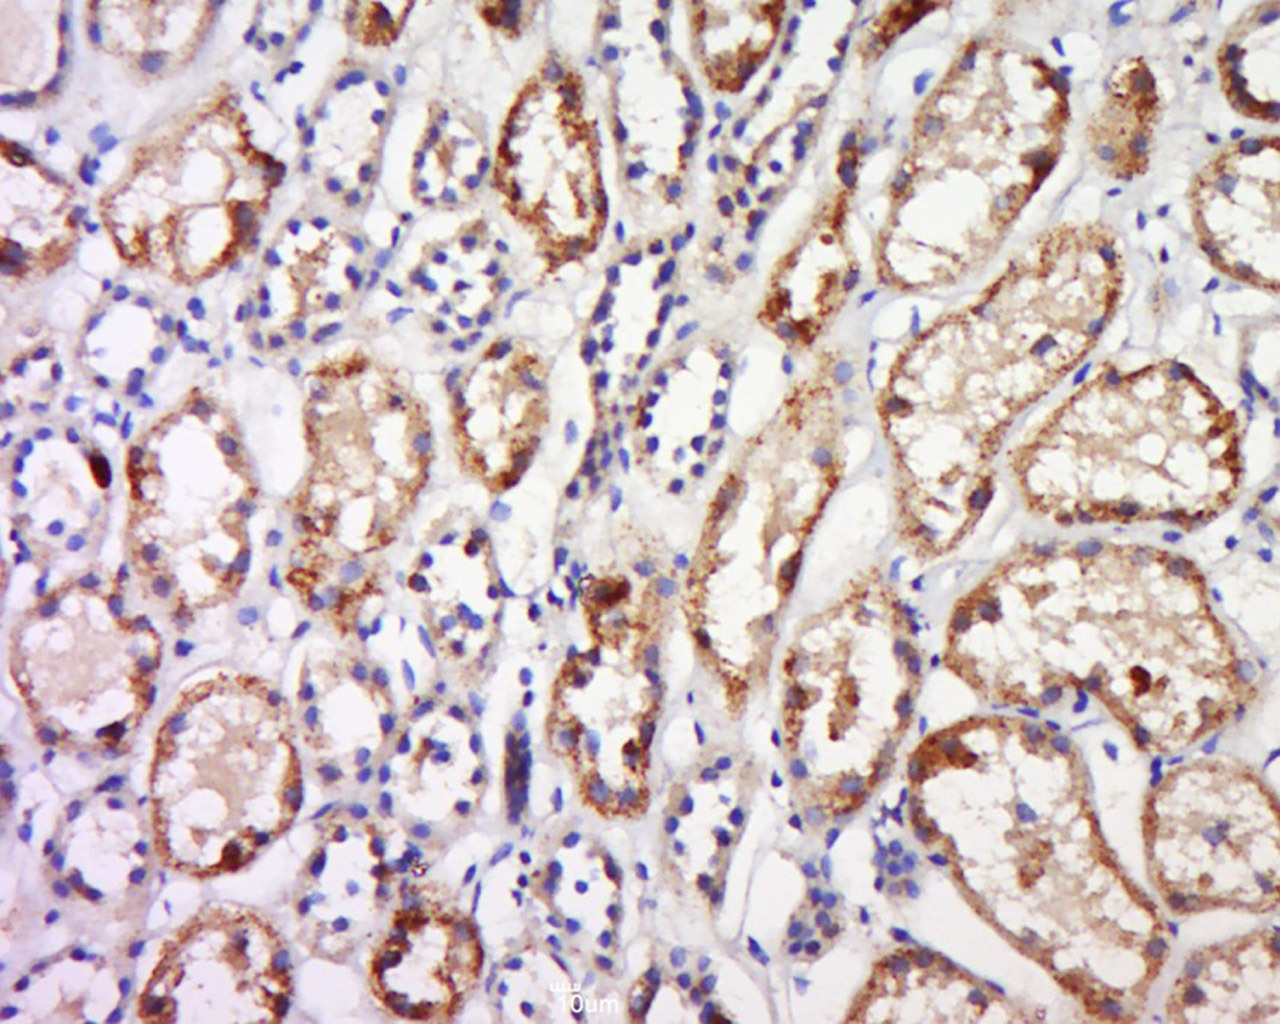
verifiedActivity

购物车
 您的购物车当前为空
您的购物车当前为空
Anti-GPR91 Polyclonal Antibody 是一种 Rabbit 抗体,靶向 Phospho-Smad1/5 (Ser463, 465)。Anti-GPR91 Polyclonal Antibody 可用于 IF,IHC-Fr,IHC-P,WB。
别名 SUCR1, SUCNR1, SUCNR 1, SUCN R1, Succinate receptor 1, Succinate receptor, Purinergic Receptor P2U2, P2Y purinoceptor 1-like, P2Y purinoceptor 1, G-protein coupled receptor 91, GPR 91
Anti-GPR91 Polyclonal Antibody 是一种 Rabbit 抗体,靶向 Phospho-Smad1/5 (Ser463, 465)。Anti-GPR91 Polyclonal Antibody 可用于 IF,IHC-Fr,IHC-P,WB。
| 规格 | 价格 | 库存 | 数量 |
|---|---|---|---|
| 50 μL | ¥ 1,175 | 5日内发货 | |
| 100 μL | ¥ 1,965 | 5日内发货 | |
| 200 μL | ¥ 2,785 | 5日内发货 |
TargetMol的所有产品仅用作科学研究或药证申报,不能被用于人体,我们不向个人提供产品和服务。请您遵守承诺用途,不得违反法律法规规定用于任何其他用途。
| 产品描述 | Anti-GPR91 Polyclonal Antibody is a Rabbit antibody targeting Phospho-Smad1/5 (Ser463, 465). Anti-GPR91 Polyclonal Antibody can be used in IF,IHC-Fr,IHC-P,WB. |
| 别名 | SUCR1, SUCNR1, SUCNR 1, SUCN R1, Succinate receptor 1, Succinate receptor, Purinergic Receptor P2U2, P2Y purinoceptor 1-like, P2Y purinoceptor 1, G-protein coupled receptor 91, GPR 91 |
| Ig Type | IgG |
| 反应种属 | Human(predicted:Mouse) |
| 验证活性 | 1. Tissue/cell: human breast cancer; 4% Paraformaldehyde-fixed and paraffin-embedded; Antigen retrieval: citrate buffer (0.01M, pH6.0), Boiling bathing for 15 min; Block endogenous peroxidase by 3% Hydrogen peroxide for 30 min; Blocking buffer (normal goat serum) at 37°C for 20 min; Incubation: Anti-GPR91 Polyclonal Antibody, Unconjugated (TMAB-00801) 1:600, overnight at 4°C, followed by conjugation to the secondary antibody and DAb staining. 2. Western blot analysis of extracts from Liver tissue (mo) using GPR91 Antibody. 3. Tissue/cell: human kidney tissue; 4% Paraformaldehyde-fixed and paraffin-embedded; Antigen retrieval: citrate buffer (0.01M, pH6.0), Boiling bathing for 15 min; Block endogenous peroxidase by 3% Hydrogen peroxide for 30 min; Blocking buffer (normal goat serum) at 37°C for 20 min; Incubation: Anti-GPR91 Polyclonal Antibody, Unconjugated (TMAB-00801) 1:600, overnight at 4°C, followed by conjugation to the secondary antibody and DAb staining. 4. Protein: 1.kidney lyates (mo);2.liver lyates (mo); Primary: Rabbit Anti-GPR91 (TMAB-00801) at 1:300; Secondary: 800CW Conjugated Goat (polyclonal) Anti-Rabbit Igg (H+L) at 1: 10000; Predicted band size:39 kDa Observed band size:49 kDa 5. Sample: HepG2 Cell (Human) Lysate at 40 μg Primary: Anti-GPR91 (TMAB-00801) at 1/300 dilution Secondary: IRDye800CW Goat Anti-Rabbit IgG at 1/20000 dilution Predicted band size: 39 kDa Observed band size: 39 kDa |
| 应用 | IFIHC-FrIHC-PWB |
| 推荐剂量 | WB: 1:500-2000; IHC-P: 1:100-500; IHC-Fr: 1:100-500; IF: 1:100-500 |
| 抗体种类 | Polyclonal |
| 宿主来源 | Rabbit |
| 亚细胞定位 | Cell membrane; Multi-pass membrane protein. |
| 组织特异性 | Expressed specifically in kidney. |
| 构建方式 | Polyclonal Antibody |
| 纯化方式 | Protein A purified |
| 性状 | Liquid |
| 缓冲液 | 0.01M TBS (pH7.4) with 1% BSA, 0.02% Proclin300 and 50% Glycerol. |
| 浓度 | 1 mg/mL |
| 研究背景 | This gene encodes a G-protein-coupled receptor for succinate, an intermediate molecule of the citric acid cycle. It is involved in the promotion of hematopoietic progenitor cell development, and it has a potential role in renovascular hypertension which has known correlations to renal failure, diabetes and atherosclerosis. [provided by RefSeq, Oct 2009] |
| 免疫原 | KLH conjugated synthetic peptide: human GPR91 |
| 抗原种属 | Human |
| 基因名称 | SUCNR1 |
| 基因ID | |
| 蛋白名称 | Succinate receptor 1 |
| Uniprot ID | |
| 研究领域 | GPCR,Other Cell Types |
| 功能 | Receptor for succinate. |
| 分子量 | Theoretical: 39 kDa. Actual: 39 kDa. |
| 储存方式 | Store at -20°C or -80°C for 12 months. Avoid repeated freeze-thaw cycles. |
| 运输方式 | Shipping with blue ice. |